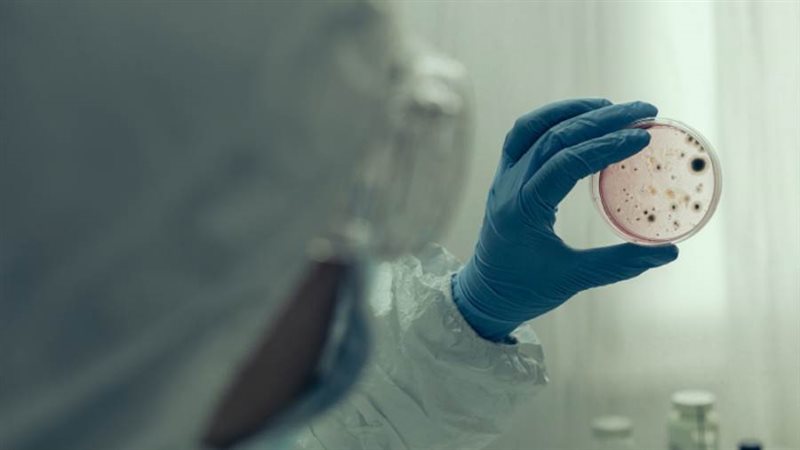
بوابة روز اليوسف

5 أساطير عن فيروس كورونا يمكن أن تؤدي إلى موجة ثانية مميتة
تزامنا مع تخفيف القيود الصارمة للإغلاق الذي دام عدة أشهر، حذر الكثيرون من اندلاع موجة ثانية من فيروس كورونا.
وشهدت العديد من الدول، بما في ذلك إسبانيا وكوريا الجنوبية وإسرائيل، طفرات جديدة من المرض، ما يشير إلى أن هناك بعض الأخطاء التي يجب الانتباه إليها خلال تخفيف الإغلاق، ومن ذلك جملة من الأساطير الخطيرة التي يمكن أن تسبب كارثة.
1. الشباب محصنون ضد "كوفيد-19":
هناك اعتقاد شائع بأن فيروس كورونا خطير على كبار السن فقط أو على البالغين. لكن في الشهر الماضي، أبلغ مستشفى شيفيلد عن وفاة أصغر ضحية لفيروس كورونا في بريطانيا، وهو طفل يبلغ من العمر 13 يوما دون أن يعاني من مشاكل صحية كامنة.
وتوفي أكثر من طفل صغير بسبب فيروس كورونا. ويُعتقد أن إجمالي 20 مريضا تقل أعمارهم عن 19 عاما ماتوا بسبب الفيروس في المستشفيات في إنجلترا.
2. لقد مر الخطر:
مع الانخفاض المستمر في عدد الوفيات التي يتم الإبلاغ عنها كل يوم، سيكون من السهل الثقة المفرطة بأن الخطر قد زال.
لكن أنتوني كوستيلو من Independent SAGE يحذر: "عمليا كل مكان يبدأ في تخفيف الإجراءات حيث يتناقض التباعد الاجتماعي، تبدأ في رؤية تفشي المرض مجددا".
وأضاف: "لا يبدو أن لدينا مناعة القطيع التي كان يأمل بوريس جونسون في أن تحمي المملكة المتحدة من تفشي الوباء. وتحتاج مناعة القطيع على الأقل إلى تعافي 60% من السكان من المرض، في حين تشير أفضل الأرقام المتاحة إلى أن 10% فقط من المتعافين يملكون أجساما مضادة للفيروس كورونا في دمائهم.
3. سيؤدي الطقس الدافئ إلى انخفاض عدد الحالات:
يمكن أن يساعد الطقس الأكثر دفئا بالتأكيد في تقليل معدلات الإصابة حيث يمكن للأشخاص قضاء المزيد من الوقت في الهواء الطلق، ويكون من الأسهل الابتعاد اجتماعيا، كما يمكن أن يتلف الفيروس بسبب عنصر الأشعة فوق البنفسجية في أشعة الشمس.
ووجدت إحدى الدراسات في الصين أن 98% من الحوادث شديدة الانتشار، حيث ارتفع عدد الإصابات فوق المعدل الطبيعي، تم تسجيلها في البيئات الداخلية.
ويمكن أن يكون المناخ عاملا مساهما في الحد من انتشار فيروس كورونا أو على العكس من ذلك، لكن الأمر المؤكد حتى الآن هو أن الانتشار في الهواء الطلق يكون أقل سهولة.
4. يمكنك التقاط المرض فقط من شخص يعاني من الأعراض:
ينتشر افيروس كورونا في الغالب في القطرات الدقيقة في السعال والعطاس في حالات نادرة، التي تنبعث من المرضى، ولكن هناك الكثير من الطرق الأخرى التي يمكن من خلالها أن يشق الفيروس طريقه من شخص لآخر.
ويمكن للفيروس البقاء على قيد الحياة في العديد من الأسطح لعدة أيام، وهناك أدلة تشير إلى أنه يمكن أن يستمر لفترة أطول في ظروف أكثر برودة وجفافا، ما يعني أننا قد نكون أمام موجة انتشار جديدة في الخريف.
وهناك أيضا دليل قوي على أن الأشخاص الذين ليس لديهم أي أعراض ملحوظة هم أكثر حاملي الفيروس فاعلية.
5. أقنعة الوجه لا تصنع فرقا:
تشير التوصيات الأساسية إلى أن تغطية الوجه إلزامية عند استخدام وسائل النقل العام ولكن هناك أدلة قوية على أن الاستخدام على نطاق أوسع سيقلل من انتشار المرض بشكل أكبر.
وأبلغت اليابان عن أكثر من 20 ألف إصابة فقط وأقل من ألف حالة وفاة، بينما الولايات المتحدة، لديها ما يقرب من ثلاثة ملايين إصابة و130 ألف حالة وفاة.
ويفسر هذا الاختلاف بأنه لدى اليابان ثقافة ارتداء اقنعة الوجه والتي تعود مباشرة إلى وباء الإنفلونزا الإسبانية عام 1919 ، بينما كانت هناك في أمريكا احتجاجات شديدة ضد ارتداء القناع.
وتقول دراسة نشرت في مجلة Proceedings of the National Academy of Science of the USA أنه حتى التحدث إلى شخص ما يمكن أن يطلق آلاف القطرات الحاملة للفيروسات.
وقال مؤلفو الدراسة: "إن ارتداء قناع بسيط من القماش يمكن أن يمنع بشكل كبير إطلاق قطرات أثناء الكلام".







